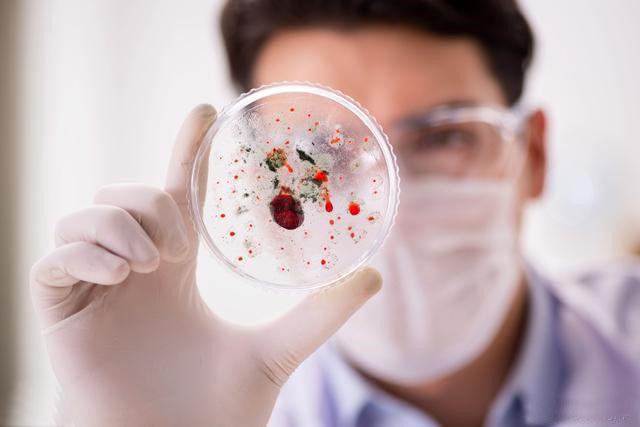

健康知识库
很多肿瘤发现的时候就是晚期, 有的是因为不重视, 有的却是没症状
编辑:ddayh.cn
- 200典型病例
- 200尊重,人最起码的道德
- 200取薏苡仁50克,百合30克,蜂蜜适
- 200入夏后空调、烧烤、火锅等引起上
- 200流感注意事项
- 200咳嗽的临床用药选择
- 200春节将至,酒和这些药很不配哦,
- 200厌氧菌肺炎的治疗方法有哪些
- 200哮喘病老人能坐飞机吗
- 200中暑发烧和普通发烧有什么症状
- 200喝板蓝根对核酸检测有影响吗
- 200大人发烧全身酸痛怎么回事
- 200春暖花开,如何预防哮喘发作?
- 200家庭日常如何预防新型冠状病毒?
- 200高反肺水肿是什么症状
- 200如何预防特发性肺纤维化
- 200慢性阻塞性肺疾病呼吸性酸中毒怎
- 200白天胸闷疲倦为何因
- 200支气管结核是怎么引起的
- 200风寒感冒发烧拉肚子是怎么回事
应该说相比较欧美发达国家,中国的癌症病人发现时晚期的比较多,5年生存率极低,也给患者心理上造成极大的阴影,大部分老百姓谈癌色变,认为患癌就是判了死缓。为什么癌症在早期难以发现呢?

1.健康意识不够 很多老百姓平时进医院次数屈指可数,没有定期做健康体检的意识,身体有点小病小痛,认为扛一扛就好了。还有这人讳疾忌医的心理,觉得病了晦气,不吉利,不想去就诊,或者不愿面对,不敢相信生病的事实。

2.肿瘤早期无明显症状 绝大多数癌症早期症状不明显,可以说癌细胞是在人毫无察觉的状态下静悄悄生长的。即便有症状也是非常常见而轻微的,比如肺癌的咳嗽,肠癌的腹泻,胃癌的上腹部不适,这些症状和普通疾病差不多,非常有迷惑性。

3.检查手段的局限性 比如常规体检的B超只能发现2cm以上的肝脏病灶,对于位置比较深的器官如胰腺等,超声不易发现。 此外,很多检查有创性较大,比如肠镜,不可能人人都做、年年都做。腹腔内的肿瘤若直径低于1-2cm,腹部CT很有可能都会漏诊,PET-CT虽然比较敏感,由于比较昂贵且辐射大,并不作为筛查肿瘤的检查手段。

4.诊断的复杂性 由于癌症确诊的金标准是病理诊断,必须取材活检或者通过手术,这种都是有创伤性的,所以一般都会先进行血液方面检查,影像学检查,在一系列的检查中也会耽误不少时间。比如有些人发现颈部淋巴结,可能病人会拒绝一开始就活检,可能会被当做炎症消炎一段时间。
所以针对有癌症家族史者、中老年人群、常接触致癌物质人群、有不良生活习惯人群、有癌前病变的患者,得更积极去进行针对性的防癌体检。
热门呼吸内科